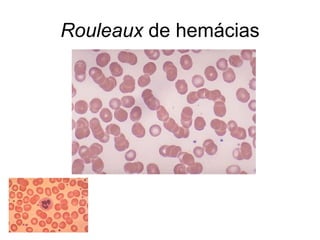
Rouleaux de hemácias

O documento discute alterações hematológicas primárias, incluindo aplasia da medula óssea, leucemias, linfomas e outras doenças mieloproliferativas. Ele fornece detalhes sobre sintomas, causas, diagnóstico e tratamento dessas condições, bem como imagens ilustrativas.